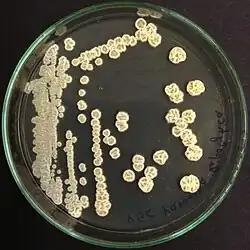

YGC-Agar
Der YGC-Agar (Abkürzung aus der englischen Bezeichnung Yeast Extract Glucose Chloramphenicol Agar für Hefeextrakt-Glucose-Chloramphenicol-Agar) ist ein Nährmedium zur Isolierung und selektiven Kultivierung von Hefen und Schimmelpilzen.
Anwendungsbereiche
Dieses Nährmedium wird durch den Internationalen Milchwirtschaftsverband (International Dairy Federation (IDF)) sowie die Internationale Organisation für Normung (ISO) für die Bestimmung des Keimgehalts von Hefen und Schimmelpilzen in Milch und Milchprodukten empfohlen[1] und daher auch als Hefeextrakt-Glucose-Chloramphenicol-Agar FIL-IDF bezeichnet.[2]
In Deutschland wird der YGC-Agar in dem vom Deutschen Institut für Normung (DIN) herausgegebenen Referenzverfahren zur Untersuchung auf Hefen und Schimmelpilze in Milch empfohlen.[3] Der Nährboden entspricht ebenfalls den Empfehlungen des Lebensmittel-, Bedarfsgegenstände- und Futtermittelgesetzbuch nach § 64 über die Amtliche Sammlung von Untersuchungsverfahren (ehemals § 35 LMBG) und wird in der Methode zur Untersuchung von Lebensmitteln; Bestimmung der Anzahl von Hefen und Schimmelpilzen in Milch und Milchprodukten; Referenzverfahren verwendet.[4]
Der YGC-Agar wird beispielsweise zum Kultivieren von Schimmelpilzen wie Aspergillus brasiliensis (ehemals A. niger), Penicillium-Arten wie Penicillium commune sowie Geotrichum candidum verwendet, ebenso für Hefen, wie Candida albicans oder Saccharomyces cerevisiae.[2] Besonders gut geeignet ist das Nährmedium für die Zählung von Hefen in Milchprodukten mit einem neutralen pH-Wert.[5]
Wirkungsweise
Das enthaltene Antibiotikum Chloramphenicol dient als Hemmstoff gegen in der Begleitflora vorhandene Bakterien. Im Gegensatz zu Nährmedien, die zu diesem Zweck den Zusatz eines anderen Antibiotikums aufweisen, kann der YGC-Agar im Autoklav sterilisiert werden, ohne dass es zu einer Beeinträchtigung kommt.[2] Eine hohe Konzentration des Kohlenhydrats Glucose fördert das Wachstum von Hefen und Schimmelpilzen, ebenso der leicht saure pH-Wert von etwa 6,6.[6] Unbeimpft ist das Nährmedium klar und gelblich. Nach der Inokulation wird das Nährmedium bis zu fünf Tage bei 25 °C inkubiert.[2]
Typische Zusammensetzung
Der Nährboden besteht meistens aus (Angaben in Gramm pro Liter):[2]
- Hefeextrakt 5,0
- D-Glucose 20,0
- Chloramphenicol 0,1
- Agar-Agar 14,9
Nährmedien
zur Kultivierung von Hefen und Schimmelpilzen kommen folgende Nährmedien infrage:
- Dichloran-Glycerin-Agar
- Kartoffel-Glucose-Agar
- Malzextrakt-Agar
- Sabouraud-Dextrose-Agar
- YM (Selektivnährboden)
Einzelnachweise
- ↑ ISO 6611:2004 (IDF 94:2004) Milk and milk products – Enumeration of colony-forming units of yeasts and/or moulds – Colony-count technique at 25 °C. In: ISO-Katalog. Oktober 2004, abgerufen am 17. März 2018.
- ↑ a b c d e PDF-File: YGC Agar (Yeast Extract Glucose Chloramphenicol Agar FIL-IDF). Merck Millipore, abgerufen am 17. März 2018.
- ↑ DIN 10186:2005-10 Mikrobiologische Milchuntersuchung – Bestimmung der Anzahl von Hefen und Schimmelpilzen – Referenzverfahren. In: Normen und Standards kaufen beim Beuth Verlag - eine DIN-Tochtergesellschaft. Oktober 2005, abgerufen am 17. März 2018.
- ↑ Technische Regel BVL L 01.00-37:1991-12 Untersuchung von Lebensmitteln; Bestimmung der Anzahl von Hefen und Schimmelpilzen in Milch und Milchprodukten; Referenzverfahren. Dezember 1991, abgerufen am 17. März 2018.
- ↑ J.J. Welthagen, B.C. Viljoen: Comparison of ten media for the enumeration of yeasts in dairy products. In: Food Research International. Band 30, Nummer 3–4, April–Mai 1997, S. 207–211, doi:10.1016/S0963-9969(97)00044-6.
- ↑ Michael T. Madigan, John M. Martinko, Jack Parker: Brock Mikrobiologie. Deutsche Übersetzung herausgegeben von Werner Goebel, 1. Auflage. Spektrum Akademischer Verlag GmbH, Heidelberg/Berlin 2000, ISBN 3-8274-0566-1, S. 813–816.